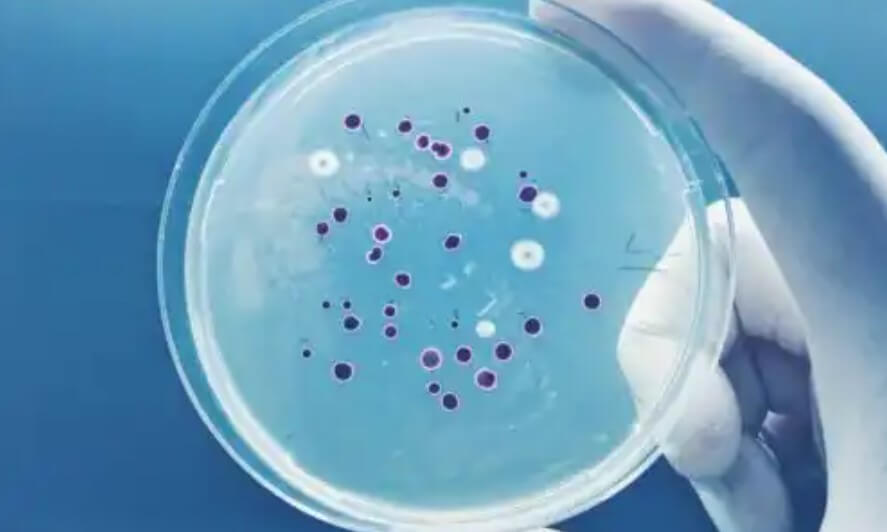

Ποικιλόχρους πιτυρίαση: Περιγραφή και χαρακτηριστικά

Το δέρμα είναι η πρώτη γραμμή άμυνας έναντι παθογόνων μικροοργανισμών και γι ‘αυτό οι μυκητιακές λοιμώξεις όπως η ποικιλόχρους πιτυρίαση είναι ένας από τους πιο συχνούς λόγους δερματολογικών συμβουλών.
Πρώτα απ ‘όλα, σημειώστε ότι ένας μεγάλος αριθμός μικροοργανισμών κατοικούν στην επιφάνεια του δέρματος και αυτοί αποτελούν μέρος του φυσιολογικού μικροβιώματος. Αυτά είναι ακίνδυνα υπό κανονικές συνθήκες, αλλά θα μπορούσαν να προκαλέσουν λοιμώξεις υπό ορισμένες συνθήκες.
Τι είναι ακριβώς η ποικιλόχρους πιτυρίαση;
Αυτή η μυκητιασική δερματική λοίμωξη, επίσης γνωστή ως Tinea versicolor, οφείλεται σε μύκητα του γένους Malassezia. Σύμφωνα με ορισμένες μελέτες, ο πιο συχνός αιτιολογικός παράγοντας μπορεί να διαφέρει ανάλογα με τη γεωγραφική θέση. Το M. globosa είναι υπεύθυνο σε εύκρατες χώρες και το M. furfur σε τροπικές χώρες.
Αυτή η κατάσταση επηρεάζει εξίσου ανθρώπους από όλα τα κοινωνικά στρώματα και έχει παγκόσμια διανομή. Ωστόσο, η μόλυνση είναι πιο συχνή σε χώρες με ζεστά υγρά κλίματα. Αυτό συμβαίνει επειδή αυτές οι καταστάσεις ευνοούν τον αποικισμό αυτού του είδους μύκητα στο δέρμα.
Τα άτομα που πλήττονται περισσότερο τείνουν να είναι νέοι και υπάρχει μέγιστη συχνότητα μεταξύ των ηλικιών 20 και 40 ετών. Ο αιτιώδης παράγοντας αποικίζει το δέρμα χωρίς να προκαλεί ζημιά. Ωστόσο, θα μπορούσε να πολλαπλασιαστεί υπό ορισμένες συνθήκες και να οδηγήσει σε μόλυνση.
Διαβάστε ακόμη: Ατοπική και σμηγματορροϊκή δερματίτιδα. Ποιες οι διαφορές;

Αιτίες
Όπως αναφέρθηκε παραπάνω, η μόλυνση οφείλεται σε μύκητα του γένους Malassezia, που είναι κοινός στο δέρμα. Στην πραγματικότητα, το Malassezia furfur έχει απομονωθεί στο 95% των περιοχών με άφθονους σμηγματογόνους αδένες σε διάφορα άτομα.
Ο μύκητας αποικίζει αυτές τις περιοχές επειδή χρειάζεται λίπος για τροφή. Έτσι, ορισμένοι παράγοντες που μπορούν να αλλάξουν τη λιπαρή σύνθεση του δέρματος θα κάνουν τον μικροοργανισμό να πολλαπλασιαστεί. Με αυτόν τον τρόπο, ο αριθμός των στελεχών του μύκητα θα αυξηθεί.
Από αυτή την άποψη, οι παρακάτω καταστάσεις μπορούν να προωθήσουν την εμφάνιση της ποικιλόχρους πιτυρίασης:
- Ένα ζεστό υγρό κλίμα
- Υπερβολική εφίδρωση και τα σφιχτά ρούχα
- Εγκυμοσύνη
- Λιπαρή επιδερμίδα
- Χρήση κορτικοστεροειδών
Επιπλέον, μια ανεπάρκεια στο ανοσοποιητικό σύστημα και η χορήγηση αντιβιοτικών μπορεί επίσης να προωθήσει την ασθένεια. Και οι δύο καταστάσεις επηρεάζουν τους μηχανισμούς ελέγχου με τους οποίους το ανθρώπινο σώμα εμποδίζει τον πολλαπλασιασμό των παθογόνων.
Ποικιλόχρους Πιτυρίαση: Συμπτώματα
Το κύριο χαρακτηριστικό αυτής της λοίμωξης είναι η εμφάνιση ωοειδών κηλίδων στο δέρμα. Αυτά τα σημεία μπορεί να είναι ελαφρύτερα ή πιο σκούρα από τον περιβάλλοντα ιστό και είναι είτε καφέ, καστανά ή λευκά.
Αυτά τα μπαλώματα μπορεί να εμφανιστούν οπουδήποτε στο σώμα, αν και συνήθως στο πίσω μέρος, στο λαιμό, στο στήθος και στο άνω μέρος του βραχίονα. Μπορεί να εμφανιστούν στις πτυχές του δέρματος και οι άνθρωποι μπορούν εύκολα να τα περάσουν για ψωρίαση.
Εκτός από τα μπαλώματα, η λοίμωξη είναι συνήθως ασυμπτωματική, αν και μπορεί να υπάρχει φαγούρα υπό ορισμένες συνθήκες – εφίδρωση, για παράδειγμα. Σημειώστε ότι η ποικιλόχρους πιτυρίαση δεν είναι ούτε επώδυνη ούτε μεταδοτική, αλλά προκαλεί μεγάλη ψυχολογική δυσφορία σε όσους υποφέρουν από αυτή.
Ίσως σας ενδιαφέρει: Πέντε τοπικές θεραπείες με βότανα για την ψωρίαση
Διάγνωση
Αυτό είναι πραγματικά πολύ απλό. Οι δερματολόγοι μπορούν να κάνουν μια ακριβή διάγνωση, κοιτάζοντας μόνο την επιδερμίδα. Ωστόσο, αυτή η κατάσταση μπορεί να εκληφθεί με άλλες δερματικές παθήσεις – όπως η σμηγματορροϊκή δερματίτιδα.
Υπάρχουν διάφορες εξετάσεις για να γίνει μια διαφορική διάγνωση, αν και η πιο συνηθισμένη είναι η άμεση παρατήρηση με μικροσκόπιο. Από αυτήν την άποψη, θα πάρουν ένα δείγμα των δερματικών κλιμάκων των βλαβών, θα τους προσθέσουν υδροξείδιο του καλίου και θα τις εξετάσουν κάτω από το μικροσκόπιο.
Σε ορισμένες περιπτώσεις, μια καλλιέργεια του δείγματος μπορεί να είναι απαραίτητη για τον μοναδικό σκοπό της διάκρισης μεταξύ των τύπων Malassezia που μπορεί να προκαλούν τη μόλυνση.
Ποικιλόχρους πιτυρίαση: Θεραπείες
Όπως αναφέραμε παραπάνω, αυτή είναι μια μυκητιακή λοίμωξη, και έτσι τα αντιμυκητιακά είναι η θεραπεία επιλογής. Σύμφωνα με ιατρικές πηγές, τα σαμπουάν και οι κρέμες είναι αποτελεσματικές στις περισσότερες περιπτώσεις. Έτσι, οι γιατροί θα πρέπει να διατηρούν συστηματική θεραπεία για ασθενείς με υποτροπή και αποτυχία της συνήθους προσέγγισης.
Όσον αφορά την τοπική θεραπεία, η χρήση κρεμών, πηκτωμάτων ή σαμπουάν με κετοκοναζόλη ή κυκλοπιρόξ έχει αποδειχθεί αποτελεσματική. Επιπλέον, η χρήση σαμπουάν θειούχου σεληνίου 2,5% είναι ευεργετική. Οι κηλίδες του δέρματος συνήθως εξαφανίζονται εντός 1 έως 2 εβδομάδων στις περισσότερες περιπτώσεις.
Η συστηματική θεραπεία πρέπει να χρησιμοποιείται σε περιπτώσεις όπου η τοπική θεραπεία δεν είναι αποτελεσματική. Από την άποψη αυτή, η φλουκοναζόλη, η κετοκοναζόλη ή η ιτρακοναζόλη μπορούν να ληφθούν από το στόμα για μια δεδομένη χρονική περίοδο.
Ποικιλόχρους πιτυρίαση: Πώς να την αποτρέψετε
Αν και προκαλείται από μύκητα που ζει στο δέρμα, υπάρχουν πολλά μέτρα που μπορούν να ληφθούν για την πρόληψη της εμφάνισης αυτής της ασθένειας. Οι περισσότερες από τις προληπτικές συμβουλές έχουν ως στόχο τη διατήρηση της σωστής προσωπικής υγιεινής και τη μείωση της ποσότητας λαδιού στο δέρμα.
Επιπλέον, λάβετε υπόψη ότι η ποικιλόχρους πιτυρίαση είναι επαναλαμβανόμενη. Επομένως, η από του στόματος λήψη αντιμυκητιασικών συνιστάται κατά τους ζεστούς μήνες με προηγούμενη ιατρική έγκριση εάν την έχετε εμφανίσει προηγουμένως.
Όλες οι παραθέτονται πηγές ελέγχθηκαν προσεκτικά από την ομάδα μας για να διασφαλιστεί η ποιότητα, η αξιοπιστία, η επικαιρότητα και η εγκυρότητά τους. Η βιβλιογραφία αυτού του άρθρου θεωρήθηκε αξιόπιστη και επιστημονικά ακριβής.
- Padilla C, Rodríguez A, Medina C, et al. Pitiriasis versicolor. Presentación de tres casos. Revista del Centro Dermatológico Pascua. 2004;13(1).
- Ramírez-Godínez J, Carreño-Gayosso E, Soto-Ortiz J, Tarango-Martínez V, Mayorga-Rodríguez J. Pitiriasis versicolor: una actualización. Medicina Cutánea Ibero-Latino-Americana. 2018; 46(3):166-170.
- Sandoval N, Arenas R, Giusiano G, et al. Diagnóstico y tratamiento de dermatofitosis y pitiriasis versicolor. Revista Médica de Honduras. 2012;80(2).
- Gómez Ayala A. Pitiriasis versicolor. Farmacia Profesional. 2009; 23(3):33-35.
- Aaron D. Tiña versicolor – Trastornos dermatológicos [Internet]. Manual MSD versión para profesionales. 2020. Available from: https://www.msdmanuals.com/es-co/professional/trastornos-dermatol%C3%B3gicos/infecciones-mic%C3%B3ticas-cut%C3%A1neas/ti%C3%B1a-versicolor.
- Personal de Mayo Clinic. Pitiriasis versicolor – Síntomas y causas [Internet]. Mayo Clinic. 2020. Available from: https://www.mayoclinic.org/es-es/diseases-conditions/tinea-versicolor/symptoms-causes/syc-20378385.
- Juárez Jiménez, MªV, et al. “Pitiriasis versicolor en Atención Primaria.”
Αυτό το κείμενο προσφέρεται μόνο για ενημερωτικούς σκοπούς και δεν αντικαθιστά τη συμβουλή από επαγγελματία. Σε περίπτωση αμφιβολίας, συμβουλευτείτε τον ειδικό σας.







